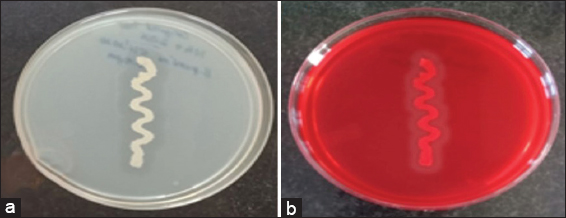

1. INTRODUCTION
Hemicellulose is the second abundant polysaccharide, which is composed of xylan. Xylan is main component of hemicellulose, presents in 20–40% of biomass from total plant and also one-third in all organic renewable carbon sources [1]. Xylan is a heteropolysaccharide with a backbone of β-1,4-glycosidic bonds with substitutes of glucuronosyl, arabinosyl, and acetyl side chains. Several enzymatic actions such as endo-1,4-β-xylanase (1,4-β-Xase) and β-1,4-xylosidase result in the conversion of hemicelluloses to xylooligosaccharides, finally to xylose [1,2]. Thus, 1,4-β-Xase is required for the degradation of hemicellulose, which is considered as potential applications for pulp and paper production, textiles, biofuels, and animal feed [3,4].
The cost of substrates for enzyme production is often restricted the growth of microorganisms, leads to inadequate enzyme production. Therefore, low-cost substrate is an alternative for the reducing the cost of production [5]. Recent studies on agriculture wastes are efficiently determined as low-cost substrates for enzyme production using various microorganisms (fungal and bacterial). Large-scale enzyme production in the presence of fungi and other microorganisms is difficult, due to its slow generation time, coproduction of high viscosity polymers, and deprived oxygen transfer. Thus, Bacillus spp. is commonly used for large-scale production of enzyme, due to its higher enzyme production with high metabolic activity. Therefore, Bacillus spp. can be used as potential organism for enzyme production [6,7]. Further enhancement in the yield of enzyme production can be operated using agro-industrial residue as natural substrate. Because, agro-industrial waste as natural substrates enhances the rate of enzyme production and also reduces the cost of production [8]. In India, the rural waste is around 625 million tonnes yearly. The rural wastes include groundnut cake, rice grain, rice straw, wheat grain, sugarcane bagasse, and so on. This waste has highest content of the hemicelluloses. The hemicellulose content in rice straw, corncob, sugarcane bagasse, and in sawdust is 24–36.80%, 35–44.4%, 26–36%, and 41.58–45%, respectively. Moreover, this waste has high rate of bioconversion of waste into useful modern products. Hence, rural wastes are possible alternative for low-cost sources for 1,4-β-Xase production [9-13].
Although, rural waste can be used as low-cost substrate, optimizing the medium and fermentation conditions are the several strategies to enhance the enzyme production. The medium optimization involves selecting the biotic components, which play a major role in the cellular metabolism for increasing the growth and production of enzyme. Selecting the biotic components is a rising task with number of combinational variables required for selecting the best combinations. However, the screening of large variables can be adopted using conventional method “Plackett–Burman Design” (P-B design) [14]. The selection can be identified based on physicochemical parameters without interaction effects between the variables. Thus, P-B design is useful for simple screening the large numbers of variables. However, the selected parameters are optimized by response surface method (RSM) for optimize the screened process variables through statistical approach. Therefore, RSM plays a critical role in designing the experimental models, variety of factors evaluation, and predicted factors for optimized condition. Furthermore, critical factors for the experiments can be designed by central composite design (CCD) [15,16]. Hence, selection of biotic and abiotic components in the fermentation media can be optimized by all the software models before experimentation [15,17,18]. The previous studies demonstrated the screening of medium composition with biotic factors by one factor at a time approach (OFAT) or fractional factorial design approach [19]. The major drawback of OFAT results in large number of experimentation, which leads to inaccurate results and also time consuming for optimizing the medium. The optimization of medium to enhance the enzyme production is not only depending on biotic factors but also on abiotic factors [20]. Therefore, our hypothesis is to develop a screening and optimization of medium components by considering both biotic and abiotic factors through P-B design and CCD, since it is a faster approach.
In the present study, we have optimized the fermentation medium composition by selecting the biotic and abiotic factors to enhance the 1,4-β-Xase production from Bacillus pumilus using low-cost rural waste substrate which was designed by P-B design and RSM followed by experimentation using shake flask studies. Xylanases are group of enzymes involved in hydrolysis of polymers, namely, arabinoxylan and xylan. We have used 1,4-β-Xase instead of xylanase, because of its stereospecificity of hydrolyzing β-1,4-glycosidic linkages [8] of xylan chain which results in short-chain xylooligosaccharides of differing lengths that are a crucial parameter for process industries.
2. MATERIALS AND METHODS
2.1. Materials
B. pumilus (MTCC) 10209, beechwood xylan (Sigma-Aldrich), and agro-industrial residues (sugarcane bagasse, corncob, rice husk, and sawdust) from in and around Davangere-577006, Karnataka, India, minimal salt yeast extract nutrient medium (MS-YENM) and other commonly used laboratory grade chemicals.
2.2. Growth Curve of 1,4-β-Xase Producing B. pumilus (MTCC) 10209
B. pumilus (MTCC) 10209 was grown on beechwood xylan agar medium on Petri plates. The inoculum was prepared by inoculating a loop full of B. pumilus in a sterile nutrient broth contained in an Erlenmeyer flask and placed in a shaker incubator at 120 rpm at 37°C for overnight [21]. Seed culture of B. pumilus of 5.6 × 105 cells per mL was further inoculated to 100 mL nutrient media and to 100 mL MS-YENM-containing beechwood xylan as a standard carbon substrate to study the growth curve and to check production time of 1,4-β-Xase. The absorbance at 600 nm was determined at each interval of time for 120 h [22,23]. The ability of B. pumilus to produce 1,4-β-Xase in beechwood xylan medium was determined by Congo red assay as per previous reports [24,25].
2.3. Determination of Carbon Source for 1,4-β-Xase Production from Rural Agro-industrial Waste
1,4-β-Xase was produced by culturing B. pumilus (MTCC) 10209 in MS-YENM-containing yeast extract (6.0 g/L), ammonium sulfate (0.1 g/L), sodium chloride (0.3 g/L), magnesium sulfate (0.1 g/L), calcium carbonate (0.02 g/L), and 1 mL trace elements solution consists of ferrous sulfate (1 g/L), zinc sulfate (0.9 g/L), and manganese sulfate (0.2 g/L). The media were supplemented with 50 g/L of rural agro-industrial wastes with approximately particle size of 1 mm (mesh size-20). The primary carbon source from rural agro-industrial wastes was sugarcane bagasse (50 g/L), corncob (50 g/L), rice husk (50 g/L), and sawdust (50 g/L) obtained from Davangere, Karnataka, India [26,27]. All these components were cleaned using tap water and distilled water followed by overnight drying in a hot air oven at 60°C. The waste was powdered and strained in the 20 mesh size before use [23].
2.4. Determination of Enzyme Activity
The crude enzyme was obtained by centrifugation at 10,000× g, 4°C for 20 min by removing insoluble particles. A 100 μL 1% (w/v) beechwood xylan (50 mM phosphate buffer, pH 7.0) and 100 μL crude enzyme were incubated for 10 min at 37°C for degradation of substrate. The degradation reaction was arrested by adding 400 μL dinitrosalicylic acid and incubated for 5 minutes in the boiling water bath. A 1 mL of phosphate buffer was added to above reaction mixture and measured the absorbance at 540 nm for the determination of 1,4-β-Xase activity using UV–Vis spectroscopy. The measurement of xylose can indirectly relate to the 1,4-β-Xase activity. Thus, the released xylose was measured at absorbance 540 nm. The release of xylose using standard substrate (beechwood xylan, Sigma-Aldrich) was determined for the estimation of 1,4-β-Xase activity. The calibration graph was obtained for standard xylose (y = 1.0007x+0.0235 and R2 = 0.9939) which was used as reference in our studies. One unit of activity of 1,4-β-Xase is defined as, enzyme amount necessary to release 1 μmol equivalent xylose for each minute per mL at the standard conditions. Bradford assay (bovine serum albumin – standard protein) was used to examine the protein content in crude enzyme [27].
2.5. Screening of Variables using P-B Design
The P-B design integrated with Design-Expert 9.0.6 software was used to screen the nine allocated factors in 12 experimental runs. The nine allocated factors were ammonium sulfate, yeast extract, magnesium sulfate, sodium chloride, zinc sulfate, calcium carbonate, manganese sulfate, ferrous sulfate, and sugarcane bagasse. Each factor was scrutinized at two concentration levels, namely, high and the low level. Based on the P-B design, fermentation medium was prepared in 100 mL of formulation distributed in the 500 mL Erlenmeyer flask. The flasks were sterilized using autoclave at 121°C for 15 min and 15 lbs. After cooling the flasks to room temperature, 1 mL of seed culture was inoculated to each flask and incubated for 26 h at 37°C in a shaker incubator at 120 rpm. All the experimental runs were conducted in triplicates. Each factor effect was estimated as the difference among the average of 1,4-β-Xase activities measured using high (+1) as well as low (−1) levels [Table 1] [28]. The screened factors from P-B design were further optimized by RSM (CCD). The coded and actual values of the variables (for biotic and abiotic factors) used in CCD are shown in Tables 2 and 3.
Table 1: Screening of the variables affecting 1, 4-β-Xase production by Bacillus pumilus (MTCC) 10209 in P-B design.
| Variable | Medium components | Low level (-1) g/L | High level (+1) g/L |
|---|---|---|---|
| X1 | Yeast extract | 4 | 10 |
| X2 | Ammonium sulphate | 0.05 | 0.2 |
| X3 | Sodium chloride | 0.15 | 0.45 |
| X4 | Magnesium sulphate | 0.05 | 0.2 |
| X5 | Calcium carbonate | 0.01 | 0.04 |
| X6 | Ferrous sulphate | 0.5 | 2 |
| X7 | Zinc sulphate | 0.45 | 1.8 |
| X8 | Manganese sulphate | 0.1 | 0.4 |
| X9 | Sugarcane bagasse | 30 | 50 |
Table 2: Coded and actual values of the variables (for biotic factors) used in central composite design.
| Independent variables | Level | ||||
|---|---|---|---|---|---|
| −a | −1 | 0 | 1 | a | |
| Yeast extract | 6 | 8 | 10 | 12 | 14 |
| Ferrous sulphate | 0.3 | 0.4 | 0.5 | 0.6 | 0.7 |
| Manganese sulphate | 0.06 | 0.08 | 0.1 | 0.12 | 0.14 |
| Sugarcane bagasse | 40 | 45 | 50 | 55 | 60 |
Table 3: Coded and actual values of the variables (for abiotic factors) used in central composite design.
| Independent variables | Level | ||||
|---|---|---|---|---|---|
| −a | −1 | 0 | 1 | a | |
| Temperature | 26.8934 | 30 | 37.5 | 45 | 48.1066 |
| pH | 4.17157 | 5 | 7 | 9 | 9.82843 |
2.6. CCD
A full factorial CCD (Design-Expert 12.0 statistical software) was applied for four biotic and two abiotic factors at five levels. The biotic variables were yeast extract, ferrous sulfate, manganese sulfate, and sugarcane bagasse. Temperature and pH were abiotic factors. The coded levels were −a, −1, 0, +1, and +a [Tables 2 and 3]. The aim of this research was also to investigate the effect of these parameters over the 1,4-β-Xase production using the regression model.
2.7. Statistical Analysis
The experimental data were performed in triplicates for P-B design (Design-Expert 9.0.6 software) and CCD (Design-Expert 12.0 statistical software, RSM with linear regression). The average value for 1,4-β-Xase production was given as dependent variable or response. 1,4-β-Xase production was examined using second-order polynomial equation and the system behavior was demonstrated [29]. The statistical parameters were estimated using analysis of variance (ANOVA), which includes the significance threshold value at P < 0.05 and the 3D contour plots were obtained.
3. RESULTS AND DISCUSSION
3.1. Primary and Secondary Screening of B. pumilus (MTCC) 10209
The production of 1,4-β-Xase has been demonstrated by various microorganisms such as yeasts, bacteria, and fungi. However, B. pumilus genus has 304 species and is highly potent for the degradation of xylan enzyme [30]. The previous studies on various species on Bacillus sp. were reported for the production of 1,4-β-Xase with different interval of time and varied medium conditions [22,31-33]. This study showed that Bacillus has high degradation ability for the production of 1,4-β-Xase. Thus, we selected B. pumilus (MTCC) 10209 as bacterial source for enzyme production. B. pumilus (MTCC) 10209 was grown in nutrient agar containing beechwood xylan standard substrate for 24 h at 37°C. The degradation ability was examined by primary screening test [Figure 1a]. The secondary screening was confirmed by Congo red test [Figure 1b] indicating that it degrades beechwood xylan. The binding of Congo red dye strongly toward beechwood xylan comprises the β-1,4-xylosidic linkages leaving the clear zone [33]. This provides the basis for a qualitative test of 1,4-β-Xase production by B. pumilus.
| Figure 1: Primary and secondary test for the production of 1,4-β-Xase from Bacillus pumilus (MTCC) 10209: (a) Bacterial growth on nutrient agar containing beechwood xylan (standard substrate), (b) Congo red test showing clear zone of inhibition; thus, it confirms the production of 1,4-β-Xase. [Click here to view] |
3.2. Optimize the Growth Conditions of B. pumilus MTCC 10209 for 1,4-β-Xase Production
The growth of B. pumilus (MTCC) 10209 was determined to understand the growth rate of B. pumilus. B. pumilus inoculum was incubated with nutrient broth at 37°C in shaker incubator at 120 rpm. At each interval of time, inoculums absorbance was measured using UV–Vis spectroscopy at 600 nm [Figure 2]. The growth curve of B. pumilus (MTCC) 10209 indicated that the doubling time of bacterium was 30 min in the nutrient broth medium and followed exponential growth phase from 3 h to 22 h. Furthermore, the previous studies on the growth of Bacillus species demonstrated that doubling time of bacterium was 30 min and reached stationary phase at 20 h with LB broth medium at 37°C, 200 rpm in a gyratory shaker [22,34]. The growth of B. pumilus (MTCC) 10209 was also studied on MS-YENM with beechwood xylan carbon source as standard substrate and the highest activity of 546 U/mL was observed at 21 h which indicates the 1,4-β-Xase is a primary metabolite.
 | Figure 2: Growth curve for Bacillus pumilus (MTCC) 10209. Growth of Bacillus pumilus (MTCC) 10209 on nutrient broth and in MS-YENM medium containing standard substrate beechwood xylan as carbon source at 37°C, 120 rpm was carried out for 120 h. The different phase was observed and represented in given graph. The 1,4-β-Xase production from Bacillus pumilus (MTCC) 10209 in MS-YENM medium was accomplished at 37°C, 120 rpm for 40 h in the presence of beechwood xylan as a standard carbon source. [Click here to view] |
3.3. Selection of Carbon Source as Natural Substrate
Carbon source from agro-industrial waste was used as natural substrate for fermentation, which is an essential component for cellular metabolism for the production of 1,4-β-Xase. B. pumilus was grown in MS-YENM with various carbon sources as natural substrates such as rice straw, sugarcane bagasse, corn cob, and sawdust at 120 rpm, 37°C for 5 days for 1,4-β-Xase production. The highest 1,4-β-Xase production in the presence of sugarcane bagasse was observed after 24 h and further incubation resulted in decreased 1,4-β-Xase activity [Figure 3]. The negligible production of 1,4-β-Xase was observed in control. The 1,4-β-Xase activity showed higher in sugarcane bagasse (1356.7 U/mL) compared to corncob (642.8 U/mL), sawdust (457.8 U/mL), and rice straw (544.8 U/mL), respectively [Figure 3]. Hemicellulose content in the sugar bagasse (26–36%) is higher compared to sawdust (26%) and rice straw (19–27%) [11,13,35]. The higher content of hemicellulose in sugarcane bagasse results in the higher growth of B. pumilus, which leads to the increased production of 1,4-β-Xase. The maximum protein content was examined in sugarcane bagasse (1.487 mg/mL) compared to corn cob (1.381 mg/mL), rice straw (1.462 mg/mL), sawdust (1.154 mg/mL), and beechwood xylan (1.2 mg/mL), respectively [Figure 4]. Since, the hemicelluloses and protein content in sugarcane bagasse was higher, which results in the higher production of 1,4-β-Xase compared to other microorganisms [27,32]. Thus, sugarcane bagasse is an alternative for standard substrate for the scale-up of value added 1,4-β-Xase product production.
 | Figure 3: Comparison of agro-residue with standard substrate. 1,4-β-Xase production from Bacillus pumilus (MTCC) 10209 in minimal salt yeast extract nutrient medium was accomplished at 37°C, 120 rpm for 5 days in the presence of agro-industrial waste such as rice straw (RS), sugarcane bagasse (SB), corn cob (CC), and sawdust (SD). The production 1,4-β-Xase with agro-industrial waste as natural substrate was compared with standard substrate (beechwood xylan). [Click here to view] |
 | Figure 4: Protein determination from agro-industrial waste: Protein production from Bacillus pumilus (MTCC) 10209 on different agro-industrial waste such as rice straw (RS), sugarcane bagasse (SB), corn cob (CC), and sawdust (SD) at 37°C, 120 rpm for 5 days. [Click here to view] |
3.4. Screening of Variables using P-B Design for 1, 4-β-Xase Production
The P-B design was used to screen the effects of nine factors in 12 experimental runs [Table 4]. The important factors for 1,4-β-Xase production were identified by the Pareto chart. The Pareto chart showed that only four factors such as yeast extract, ferrous sulfate, manganese sulfate, and sugarcane bagasse significantly influence the production of 1,4-β-Xase by B. pumilus [Figure 5]. The highest production of 1,4-β-Xase was observed at 9th run (1911 U/mL) in the presence of yeast extract, ferrous sulfate, manganese sulfate, and sugarcane bagasse at higher level. However, the lowest production of 1,4-β-Xase was observed at 2nd run (373 U/mL), contributed due to the lower levels of yeast extract and sugarcane bagasse. Thus, P-B design suggests that yeast extract and sugarcane bagasse are the important factors for nitrogen and carbon sources, respectively. ANOVA results determined that yeast extract, ferrous sulfate, manganese sulfate, and sugarcane bagasse are more significant factors (P < 0.050) with larger value of F [Table 5]. Therefore, it is confirmed that all the four factors contributed for highest production of 1,4-β-Xase.
Table 4: P-B design matrix for screening of variables (nine factors and two dummy variables, D1 and D2) affecting 1, 4-β-Xase production by Bacillus pumilus (MTCC) 10209.
| Run number | Variables (g/L) | 1,4-β-Xase activity (U/mL) | |||||||||||
|---|---|---|---|---|---|---|---|---|---|---|---|---|---|
| X1 | X2 | X3 | X4 | X5 | X6 | X7 | X8 | X9 | D1 | D2 | Experimental | Predicted | |
| 1 | 1 | 1 | −1 | 1 | 1 | 1 | −1 | −1 | −1 | 1 | −1 | 1320 | 1317.33 |
| 2 | −1 | 1 | 1 | −1 | 1 | 1 | 1 | −1 | −1 | −1 | 1 | 373 | 375.67 |
| 3 | 1 | −1 | 1 | 1 | −1 | 1 | 1 | 1 | −1 | −1 | −1 | 965 | 962.33 |
| 4 | −1 | 1 | −1 | 1 | 1 | −1 | 1 | 1 | 1 | −1 | −1 | 456 | 453.33 |
| 5 | −1 | −1 | 1 | −1 | 1 | 1 | −1 | 1 | 1 | 1 | −1 | 533 | 530.33 |
| 6 | −1 | −1 | −1 | 1 | −1 | 1 | 1 | −1 | 1 | 1 | 1 | 674 | 676.67 |
| 7 | 1 | −1 | −1 | −1 | 1 | −1 | 1 | 1 | −1 | 1 | 1 | 1592 | 1594.67 |
| 8 | 1 | 1 | −1 | −1 | −1 | 1 | −1 | 1 | 1 | −1 | 1 | 1254 | 1256.67 |
| 9 | 1 | 1 | 1 | −1 | −1 | −1 | 1 | −1 | 1 | 1 | −1 | 1911 | 1908.33 |
| 10 | −1 | 1 | 1 | 1 | −1 | −1 | −1 | 1 | −1 | 1 | 1 | 397 | 399.67 |
| 11 | 1 | −1 | 1 | 1 | 1 | −1 | −1 | −1 | 1 | −1 | 1 | 1432 | 1434.67 |
| 12 | −1 | −1 | −1 | −1 | −1 | −1 | −1 | −1 | −1 | −1 | −1 | 569 | 566.33 |
 | Figure 5: Screening of variables from P-B design. Pareto chart was obtained from P-B design, which was used to screening of different variables that affect the production of 1,4-β-Xase by Bacillus pumilus (MTCC) 10209. [Click here to view] |
Table 5: Analysis of variance for the P-B model showing the significance.
| Source | Sum of square | Degree of freedom | Mean of square | Fischer | P>F | Remarks |
|---|---|---|---|---|---|---|
| Model | 3.08×106 | 10 | 3.08×105 | 3603.5 | 0.013 | significant |
| Residual | 85.33 | 1 | 85.33 | |||
| Corrected total | 3.08E+06 | 11 |
3.5. Significant Variables Optimization by CCD
Table 6 shows the four factors with maximum and minimum levels according to the CCD (RSM). The experimental responses from 30 runs for biotic factors were examined by quadratic model with 2nd order polynomial equation. This model was used to determine the optimum concentration and the relationship among the variables mainly – sugarcane bagasse, yeast extract, ferrous sulfate, and manganese sulfate. Maximum production of 1,4-β-Xase was observed at 6th run (2060 U/mL) with yeast extract (10 g/L), ferrous sulfate (0.5 g/L), manganese sulfate (0.1 g/L), and sugarcane bagasse (50 g/L). The highest predicted value of 1,4-β-Xase production in run 6 was 1928.2 U/mL [Table 6]. Based on the CCD (RSM), biotic factors were optimized to increase the growth of B. pumilus, lead to highest production of 1,4-β-Xase. The surface response plots for biotic factors such as carbon source (sugarcane bagasse), nitrogen source (yeast extract), and salts in CCD are shown in Figure 6.
Table 6: Central composite design matrix of biotic factors and the corresponding values (experimental and predicted) for the 1, 4-β-Xase production.
| Run | Factor 1 A: (Yeast Extract) (g/L) | Factor 2 B: (Ferrous Sulphate) (g/L) | Factor 3 C: (Manganese Sulphate) (g/L) | Factor 4 D: (Sugarcane Bagasse) (g/L) | Response 1 (1,4-b-Xase Activity) (U/mL) | |
|---|---|---|---|---|---|---|
| Experimental | Predicted | |||||
| 1 | 12 | 0.6 | 0.08 | 55 | 479 | 406.36 |
| 2 | 12 | 0.4 | 0.12 | 45 | 789 | 952.75 |
| 3 | 10 | 0.5 | 0.06 | 50 | 636 | 741.81 |
| 4 | 10 | 0.5 | 0.1 | 50 | 1944 | 1928.2 |
| 5 | 12 | 0.6 | 0.12 | 55 | 558 | 599.58 |
| 6 | 10 | 0.5 | 0.1 | 50 | 2060 | 1928.2 |
| 7 | 10 | 0.5 | 0.1 | 50 | 1990 | 1928.2 |
| 8 | 12 | 0.4 | 0.08 | 45 | 408 | 372.03 |
| 9 | 10 | 0.3 | 0.1 | 50 | 512 | 445.66 |
| 10 | 8 | 0.4 | 0.08 | 55 | 842 | 793.69 |
| 11 | 12 | 0.4 | 0.08 | 55 | 340 | 348.23 |
| 12 | 12 | 0.6 | 0.12 | 45 | 1081 | 1047.38 |
| 13 | 10 | 0.5 | 0.1 | 50 | 1882 | 1928.2 |
| 14 | 8 | 0.6 | 0.08 | 55 | 868 | 782.57 |
| 15 | 8 | 0.4 | 0.08 | 45 | 386 | 422.74 |
| 16 | 8 | 0.6 | 0.12 | 55 | 577 | 531.04 |
| 17 | 8 | 0.6 | 0.08 | 45 | 462 | 452.36 |
| 18 | 12 | 0.4 | 0.12 | 55 | 618 | 545.71 |
| 19 | 10 | 0.5 | 0.1 | 60 | 366 | 458.49 |
| 20 | 14 | 0.5 | 0.1 | 50 | 469 | 471.83 |
| 21 | 8 | 0.6 | 0.12 | 45 | 514 | 584.09 |
| 22 | 10 | 0.5 | 0.1 | 50 | 1791 | 1928.2 |
| 23 | 10 | 0.5 | 0.14 | 50 | 1173 | 1071.01 |
| 24 | 6 | 0.5 | 0.1 | 50 | 453 | 453.99 |
| 25 | 10 | 0.5 | 0.1 | 40 | 624 | 535.33 |
| 26 | 8 | 0.4 | 0.12 | 45 | 568 | 558.71 |
| 27 | 8 | 0.4 | 0.12 | 55 | 460 | 546.42 |
| 28 | 10 | 0.5 | 0.1 | 50 | 1902 | 1928.2 |
| 29 | 12 | 0.6 | 0.08 | 45 | 479 | 470.93 |
| 30 | 10 | 0.7 | 0.1 | 50 | 459 | 529.16 |
 | Figure 6: Optimization of biotic factors from CCD. The interaction between each factor was carried out for 22 h of incubation using response surface method (CCD). However, the 1,4-β-Xase activity with B. pumilus (MTCC) 10209 was found at 14th h of incubation. (a) Interaction between yeast extract and ferrous sulfate, (b) interaction between yeast extract and manganese sulfate, (c) interaction between ferrous sulfate and manganese sulfate, (d) interaction between sugarcane bagasse and yeast extract, (e) interaction between ferrous sulfate and sugarcane bagasse, and (f) interaction between manganese sulfate and sugarcane bagasse. The maximum production of 1,4-β-Xase by B. pumilus (MTCC) 10209 was optimized for biotic factors from RSM (CCD). [Click here to view] |
3.6. RSM for Optimization of Biotic Factors
The optimum value of nitrogen source (yeast extract), carbon source (sugarcane bagasse), and salts (manganese sulfate and ferrous sulfate) for 1,4-β-Xase production in shake flask studies using B. pumilus MTCC 10209 was determined by RSM (CCD). Each one of the variables was studied at five coded levels [Table 2]. At central point, the variables were coded as “0.” The predicted and experimentally observed values of 1,4-β-Xase activity by CCD are shown in Table 6. The responses were fitted with quadratic equation (1). The overall polynomial quadratic equation for 1,4-β-Xase production was:
R1 = +1928.17A + 4.46B + 82.29C - 19.21D + 17.31AB + 111.19AC98.69AD - 1.06BC - 10.19BD - 95.81CD - 366.32 A² - 360.20 B² - 255.45 C² - 357.82 D² (1)
Where, R1 – 1,4-β-Xase activity, A – yeast extract, B – ferrous sulfate, C – manganese sulfate, and D – sugarcane bagasse.
The ANOVA for quadratic model indicated in Table 7 (biotic factors). The ANOVA results showed that the linear terms as – yeast extract and manganese sulfate, yeast extract and sugarcane bagasse, manganese sulfate, and sugarcane bagasse; square terms as – yeast extract, ferrous sulfate, manganese sulfate, and sugarcane bagasse; and manganese sulfate are significant (P < 0.05) model terms for 1,4-β-Xase production.
Table 7: Analysis of variance for quadratic model (biotic factors).
| Source | Sum of squares | df | Mean square | F | P |
|---|---|---|---|---|---|
| Model | 9.576E+06 | 14 | 6.840E+05 | 65.07 | <0.0001 Significant |
| A (Yeast Extract) | 477.04 | 1 | 477.04 | 0.0454 | 0.8342 Not significant |
| B (Ferrous Sulphate) | 10458.38 | 1 | 10458.38 | 0.9948 | 0.3344 Not significant |
| C (Manganese Sulphate) | 1.625E+05 | 1 | 1.625E+05 | 15.46 | 0.0013 Significant |
| D (Sugarcane Bagasse) | 8855.04 | 1 | 8855.04 | 0.8423 | 0.3733 Not significant |
| AB | 4795.56 | 1 | 4795.56 | 0.4562 | 0.5097 Not significant |
| AC | 1.978E+05 | 1 | 1.978E+05 | 18.82 | 0.0006 Significant |
| AD | 1.558E+05 | 1 | 1.558E+05 | 14.82 | 0.0016 Significant |
| BC | 18.06 | 1 | 18.06 | 0.0017 | 0.9675 Not significant |
| BD | 1660.56 | 1 | 1660.56 | 0.1580 | 0.6966 Not significant |
| CD | 1.469E+05 | 1 | 1.469E+05 | 13.97 | 0.0020 Significant |
| A² | 3.681E+06 | 1 | 3.681E+06 | 350.12 | <0.0001 Significant |
| B² | 3.559E+06 | 1 | 3.559E+06 | 338.51 | <0.0001 Significant |
| C² | 1.790E+06 | 1 | 1.790E+06 | 170.25 | <0.0001 Significant |
| D² | 3.512E+06 | 1 | 3.512E+06 | 334.06 | <0.0001 Significant |
| Residual | 1.577E+05 | 15 | 10512.67 | ||
| Lack of fit | 1.146E+05 | 10 | 11460.53 | 1.33 | 0.3966 Not significant |
| Pure error | 43084.83 | 5 | 8616.97 | ||
| Corrected total | 9.734E+06 | 29 |
The statistical significance was determined by the F-test for the model equation, in which the regression was statistically significant with 98.38% confidence level. F-value was 65.07 and the P-value was < 0.0001, which showed significant effect on the 1,4-β-Xase production. The R2 (coefficient of determination) was 0.9838, which indicates that the model might explain up to 98.38% of variability. The values obtained (both experimental and predicted) are in good agreement with this model. Adequate precision (measure of signal to noise ratio) value is <4.0. The signal-to-noise ratio of 21.792 indicates an adequate signal and hence can be used to navigate the design space. Thus, the quadratic model was significant for 1,4-β-Xase production.
The 3D and contour (response surface plots) plots were analyzed by interactions between the variables and optimum value for each of the factor for maximum 1,4-β-Xase production. Each plot shows the combined effect of two variables keeping the remaining variables at “0” (central) level.
Analysis of the 3D response surface plot between yeast extract and ferrous sulfate [Figure 6a], manganese sulfate, and yeast extract [Figure 6b], manganese sulfate and ferrous sulfate [Figure 6c], sugarcane bagasse and yeast extract [Figure 6d], sugarcane bagasse and ferrous sulfate [Figure 6e], and sugarcane bagasse and manganese sulfate [Figure 6f] showed maximum 1,4-β-Xase activity at the central level (“0” level) and further increase (“+1” level) or decrease (“-1” level) significantly decreased the 1,4-β-Xase activity. From response surface quadratic model, the optimum values observed for four factors were 10 g/L yeast extract, 50 g/L sugarcane bagasse, 0.1 g/L manganese sulfate, and 0.5 g/L ferrous sulfate of the production medium. The remaining medium components with their concentrations were kept same as used in the original fermentation medium. The CCD experimental value of 1,4-β-Xase activity (2060 U/ml) was observed to be close to the predicted value (1928.2 U/ml). The 1,4-β-Xase production using CCD optimized medium with biotic factors was 1.52-fold higher than unoptimized medium.
As the concentration of sugarcane bagasse increased, it absorbs the water in the medium and decreasing the free water. Depending on the water available, the swelling of agro-industrial residue will vary and also affecting the nutrients uptake by the microorganisms required for the growth and other metabolic activities [36]. The sugarcane bagasse is a good source of hemicellulose consisting of branched heteropolymers, namely, xylose and arabinose, hexoses such as mannose, galactose glucose, and uronic acids. This substrate together with nitrogen source and other salts in the medium at optimum level contributes for increased 1,4-β-Xase production [17]. As shown in Figure 6, the increase in substrate concentration with nitrogen source and salts increases to maximum, further increase in the concentration leads to substrate inhibition, leading to decrease in 1,4-β-Xase production. The microbial growth and its metabolism are regulated by nitrogen source, thereby varying the enzyme production. The pH of the fermentation medium may significantly be affected by the nitrogen source thereby influencing the protein production [17,37]. Yeast extract is a complex nitrogen source with many growth factors which enhances the bacterial growth and influences the enzyme production [7].
Figure 6 shows the variation of 1,4-β-Xase production by the variation of yeast extract concentration. The salt concentration, namely, ferrous sulfate and manganese sulfate, greatly affects the 1,4-β-Xase production. The ferrous sulfate acts as an inducer for maximum 1,4-β-Xase production [38]. The combined effect of salts with nitrogen and carbon source enhances the enzyme production.
A 1,4-β-Xase production from B. pumilus showed higher production compared to other microbial sources such as Aspergillus fumigatus (1620 U/ml) and B. pumilus AB-1 (843.56 U/g) using wheat bran as natural substrate using CCD optimized fermentation medium components [28,39].
3.7. RSM for Optimization of Abiotic Factors
The abiotic factors such as temperature and pH were optimized in 13 experiments. The highest 1,4-β-Xase activity value (2088 U/mL) in 4th run was observed at 37.5°C, pH 7 and the predicted value was 2052 U/mL [Table 8] at same temperature and pH.
Table 8: Central composite design matrix of abiotic factors and the corresponding values (experimental and predicted) for the 1, 4-β-Xase production.
| Run | A: A (Temperature) °C | B: B (pH) | Response 1 (1,4-b-Xase activity) (U/mL) | |
|---|---|---|---|---|
| Experimental | Predicted | |||
| 1 | 48.1066 | 7 | 37.75 | 33.35 |
| 2 | 37.5 | 7 | 2069 | 2052.2 |
| 3 | 26.8934 | 7 | 218 | 257.47 |
| 4 | 37.5 | 7 | 2088 | 2052.2 |
| 5 | 30 | 9 | 453 | 389.69 |
| 6 | 45 | 9 | 527 | 494.72 |
| 7 | 37.5 | 9.82843 | 645 | 705.33 |
| 8 | 37.5 | 7 | 2065 | 2052.2 |
| 9 | 37.5 | 7 | 1984 | 2052.2 |
| 10 | 45 | 5 | 88 | 116.24 |
| 11 | 37.5 | 4.17157 | 568 | 542.73 |
| 12 | 30 | 5 | 541 | 538.22 |
| 13 | 37.5 | 7 | 2055 | 2052.2 |
The overall polynomial quadratic equation (2) for 1,4-β-Xase production was:
R1 = +2052.20 - 79.24A + 57.49B + 131.75AB - 953.40A² - 714.08B² (2)
Where, R1 – 1,4-β-Xase activity, A – temperature, and B – pH.
The ANOVA for 1,4-β-Xase production (for abiotic factors) obtained [Table 9] with R2 of 0.9980. The model F-value of 690.87 (P < 0.0001) implies that the model for abiotic factors is significant. In this case, the squared terms of temperature and pH were more significant model terms than linear terms (temperature, pH, and combined effect of temperature and pH). The response plots of abiotic factors temperature and pH are shown in Figure 7. With increase in temperature and pH, the 1,4-β-Xase production increases and found maximum at “0” level (temperature 37.5°C and pH 7), thereafter the production declines.
Table 9: Analysis of variance for quadratic model (abiotic factors).
| Source | Sum of squares | df | Mean square | F | P |
|---|---|---|---|---|---|
| Model | 8.93×106 | 5 | 1.79×106 | 690.87 | <0.0001 Significant |
| A-A (Temperature) | 50230.55 | 1 | 50230.55 | 19.43 | 0.0031 Significant |
| B-B (pH) | 26437.86 | 1 | 26437.86 | 10.23 | 0.0151 Significant |
| AB | 69432.25 | 1 | 69432.25 | 26.86 | 0.0013 Significant |
| A² | 6.32×106 | 1 | 6.32×106 | 2445.83 | <0.0001 Significant |
| B² | 3.55×106 | 1 | 3.55×106 | 1372.08 | <0.0001 Significant |
| Residual | 18097.17 | 7 | 2585.31 | ||
| Lack of fit | 11710.37 | 3 | 3903.46 | 2.44 | 0.2039 Not significant |
| Pure error | 6386.8 | 4 | 1596.7 | ||
| Corrected total | 8.95×106 | 12 |
 | Figure 7: Optimization of abiotic factors from CCD. The abiotic factors such as temperature and pH were optimized using RSM (CCD). 1,4-β-Xase production by B. pumilus (MTCC) 10209 after 14 h of incubation with optimized abiotic factors was obtained from RSM (CCD). [Click here to view] |
B. pumilus AB-1 on agro-industrial residue (wheat bran, sugarcane bagasse, and sawdust) produced maximum 1,4-β-Xase 843.56 U/g at 37°C, pH 7 [39]. Hence, the present work highlights the highest 1,4-β-Xase production by B. pumilus MTCC 10209 within 14th h of incubation period with optimized biotic and abiotic factors and use of agro-industrial waste as substrate makes the product economical. These findings illustrate the novelty to the present work.
The CCD experimental value of 1,4-β-Xase activity (2088 U/ml) was observed to be close to the predicted value (2052.2 U/ml). The 1,4-β-Xase production using CCD optimized medium with abiotic factors was 1.54-fold higher than unoptimized medium. Thus, the effect of biotic and abiotic factors on the 1,4-β-Xase activity production was observed and is reflected in quadratic equations in linear, interaction, and square terms.
Hence, optimization through CCD experiments showed maximum 1,4-β-Xase activity (2088 U/ml) after 14 h incubation at 37.5°C and pH 7 with agitation of 120 rpm in the fermentation medium containing sugarcane bagasse (50 g/L), yeast extract (10.0 g/L), ammonium sulfate (0.1 g/L), sodium chloride (0.3 g/L), magnesium sulfate (0.1 g/L), calcium carbonate (0.02 g/L), and 1 mL trace elements solution consisting of ferrous sulfate (0.5 g/L), zinc sulfate (0.9 g/L), and manganese sulfate (0.1 g/L) and inoculated with 1 % of 16-h-old seed culture.
3.8. Validation
Experiments were conducted in triplicates. From P-B design and CCD, the statistical optimum values of the variables were determined and the response yielded maximum 1,4-β-Xase production. RSM studies have optimized the fermentation medium with sugarcane bagasse for the maximum production of 1,4-β-Xase using B. pumilus MTCC 10209.
4. CONCLUSION
The highest 1,4-β-Xase (2088 U/ml) was produced from B. pumilus MTCC 10209 using optimized fermentation medium with sugarcane bagasse as low-cost natural substrate. The fermentation medium was optimized by P-B design and RSM (CCD). Our studies showed that 1.54-fold higher 1,4-β-Xase production than unoptimized fermentation medium. Fermentation time was reduced from 24 h to 14 h using optimized medium. Thus, our study replaced conventional OFAT approach. Sugarcane bagasse can be used as natural substrate from agro-industrial waste for higher production of 1,4-β-Xase for industrial applications.
5. ACKNOWLEDGMENTS
Varsha D Savanth acknowledges Ph.D Research Assistantship from Sree Siddaganga Education Society (SSES), Tumkur.
6. AUTHORS’ CONTRIBUTIONS
All authors have made considerable contributions in investigation, formulation, methodology, original draft preparation, supervision, idea generation, interpreting the data, and conceptualization and approved for final version to be published. According to ICMJE guidelines, all authors are eligible to authorship.
7. FUNDING
There is no funding to report.
8. CONFLICTS OF INTEREST
The authors report no financial or any other conflicts of interest in this work.
9. ETHICAL APPROVALS
This research work does not involve studies on animals and/or human subject.
10. DATA AVAILABILITY
The authors confirm that the findings and data of the present study are available within the manuscript.
11. PUBLISHER’S NOTE
This journal remains neutral with regard to jurisdictional claims in published institutional affiliation.
REFERENCES
1. Oyedeji O, Iluyomade A, Egbewumi I, Odufuwa A. Isolation and screening of xylanolytic fungi from soil of botanical garden:Xylanase production from
2. Bhardwaj N, Kumar B, Verma P. A detailed overview of xylanases:An emerging biomolecule for current and future prospective. Bioresour Bioprocess 2019;6:40. [CrossRef]
3. Feher A, Bedo S, Feher C. Comparison of enzymatic and acidic fractionation of corn fiber for glucose-rich hydrolysate and bioethanol production by
4. Musbah A, Ahmed S, Alfonso K, Noori B, Saady MC. Adapting anaerobic consortium to pure and complex lignocellulose substrates at low temperature:Kinetics evaluation. Int J Recycl Org Waste Agric 2019;8:99-110. [CrossRef]
5. Rosmine E, Sainjan NC, Silvester R, Varghese SA. Utilisation of agrowastexylan for the production of industrially important enzyme xylanase from aquatic
6. Boucherba N, Gagaoua M, Darenfed AB, Bouiche C, Bouacem K, Kerbous MY,
7. Anand A, Kumar V, Satyanarayana T. Characteristics of thermostable endoxylanase and b-xylosidase of the extremely thermophilic bacterium
8. Richhariya J, Sharma TK, Dassani S. Production and optimization of enzyme xylanase by
9. Knob A, Fortkamp D, Prolo T, Izidoro SC, Almeida JM. Agro-residues as alternative for xylanase production by filamentous fungi. Bioresources 2014;9:5738-73.
10. Shen F. Tian L, Yuan H, Pang Y, Chen S, Zou D,
11. Guzman A, Delvasto S, Sanchez E. Valorization of rice straw waste:An alternative ceramic raw material. Ceramica 2015;61:126-36. [CrossRef]
12. Chavez-Rosales JS, Pintor-Ibarra LF, Ortega NG, Equihua RO, Aquino FR, Alvarez CL,
13. Ioelovich M. Methods for determination of chemical composition of plant biomass. J SITA 2015;17:208-14.
14. Shah P, Modi H. Statistical optimization of culture conditions for enhanced mycelial biomass production using
15. Maravi P, Kumar A. Optimization and statistical modeling of microbial cellulase production using submerged culture. J Appl Biol Biotechnol 2021;9:142-52.
16. Kamaraj M, Subramaniam D. Amylase production by
17. Kandiyil S, Malek RA, Aziz R, Enshasy HA. Development of an industrially feasible medium for enhanced production of extremely thermophilic recombinant endo-1,4-b-xylanase by
18. Dhanker R, Chaudhary S, Tomar SK, Goyal S. Ethanol production by
19. Geetha K, Gunasekaran P. Optimization of nutrient medium containing agricultural waste for xylanase production by
20. Khusro A, Barathi KK, NaifAbdullah AD, Mariadhas VA, Paul A. Statistical optimization of thermo-alkali stable xylanase production from
21. Kumar L, Kumar D, Nagar S, Gupta R, Garg N, Kuhad RC,
22. Rajesh D, Karthikeyan S, Jayaraman G. Isolation and partial characterization of a new bacteriocin from
23. Geetha K, Gunasekaran P. Purification of endoxylanase from
24. Bibi Z, Ansari A, Zohra RR, Aman A, Qader SA. Production of xylan degrading endo-1, 4-b-xylanase from thermophilic
25. Wickramasinghe GH, Rathnayake PP, Chandrasekharan NV, Weerasinghe MS, Wijesundera RL, Wijesundera WS. Expression, docking, and molecular dynamics of endo-b-1,4-xylanase i gene of
26. Mohlala LM, Bodunrin MO, Awosusi AA, Daramola MO, Cele NP, Olubambi PA. Beneficiation of corncob and sugarcane bagasse for energy generation and materials development in Nigeria and South Africa:A short overview. Alexandria Eng J 2016;55:3025-36. [CrossRef]
27. Adigüzel AO, Tuncer M. Production and characterization of partially purified thermostable endoxylanase and endoglucanase from novel
28. Abdella A, Segatod F, Wilkinsb MR. Optimization of nutrient medium components for production of a client endo-b-1,4-xylanase from
29. Ali RS, Muthuvelayudham R, Viruthagiri T. Statistical optimization of medium components for hemicellulase production using Tapioca stem. J Microbiol Biotechnol Food Sci 2013;2:2377-82.
30. Garcia-Ramon DC, Molina CA, Osuna A, Vílchez S. An in-depth characterization of the entomopathogenic strain
31. Ghosh A, Mahanta S, Banerjee S, Baishy D. Exploration of endo-xylanase from novel strain of
32. Kumar V, Syal P, Satyanarayana T. Highly thermo-halo-alkali-stable b-1,4-endoxylanase from a novel polyextremophilic strain of
33. Deshmukh RA, Jagtap S, Mandal MK, Mandal SK. Purification, biochemical characterization and structural modelling of alkali-stable b-1,4-xylan xylanohydrolase from
34. Rhee MS, Wei L, Sawhney N, Rice JD, Franz J, John S,
35. Singh AB, Enhanced production of bacterial xylanase and its utility in saccharification of sugarcane bagasse. Bioprocess Biosyst Eng 2020;43:1081-91. [CrossRef]
36. Desai DI, Iyer BD. Optimization of medium composition for cellulase-free xylanase production by solid-state fermentation on corn cob waste by
37. Bajaj BK, Sharma M, Sharma S. Alkalistable endo-b-1, 4-xylanase production from a newly isolated alkalitolerant
38. Begam AM, Annu A, Banu SS, Priya VD. Comparison and optimization of thermostable xylanase production by
39. Ingale S, S Kalyani S, Chhaya U. Application of statistical design to optimize culture medium for xylanase production by